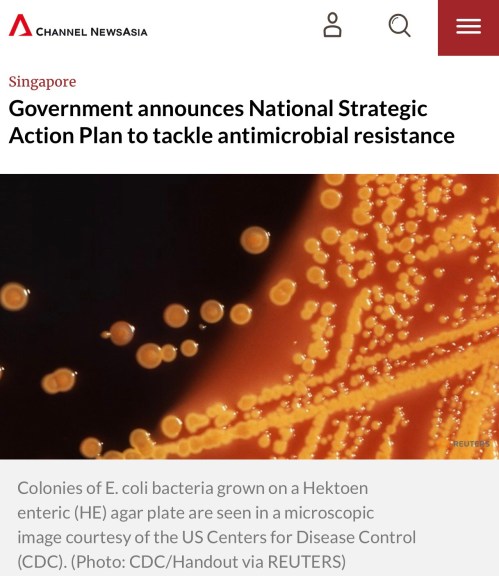

The European Society of Clinical Microbiology & Infectious Diseases (ESCMID) regularly organizes educational courses, the vast majority of which are held in Europe. This year, however, their postgraduate course on tuberculosis and mycobacterial disease was held in Singapore from 26th to 28th September, in NUS. Although other specialties (particularly the oncologists) have organized regional editions […]

The Institute of Tropical Medicine, Antwerp (Belgium) has been organizing annual colloquia since 1959. This year’s colloquium was on antibiotic resistance, and was held in Phnom Penh, Cambodia, from 5th to 7th December. I was fortunate enough to be invited for the event, which featured speakers from the ITM (naturally) as well as regional and […]
Primarily organised by the Lee Kong Chian School of Medicine, this event took place during World Antibiotic Awareness Week on 13th and 14th November. There were a lot of great regional and local speakers, and the event was well attended even by officials from local ministries – always a good sigh for the National Strategic […]
I had the honour of being invited to attend the workshop and seminar in Putrajaya, Kuala Lumpur, Malaysia. This event – held today and tomorrow – is organized by the Ministry of Health Malaysia in collaboration with the US Embassy in Malaysia as well as the World Health Organization (WHO). It was a far larger […]
The 13th edition of Singapore’s Public Health & Occupational Medicine Conference (or PHOM as it is called) was held at the One Farrer Hotel on 4th and 5th of October. I had attended a few of the earlier editions, and the number of attendees has increased with each year. The public health community in Singapore […]
The abovementioned conference was held at the Khanh Hoa Convention Centre (the main auditorium resembles concert theatre) in Nha Trang, Vietnam. The primary organisers were the National Hospital for Infectious Diseases (NHTD), Vietnam Society of Infectious Diseases (VSID), Vietnam Clinical of HIV/AIDS Society (VCHAS), Vietnam Society of Parasitology (VSP), Oxford Clinical Research Unit Vietnam (OUCRU), […]
A personal and primarily local look back at the year. What are the major infectious diseases events in modern Singapore in 2017? Outbreaks The World Health Organization (WHO) has a list of outbreaks by year on its website, and the 2017 list is depressingly long. There are the usual “suspects” like cholera (Africa) and diphtheria […]
I was privileged to be invited for the Singapore Centre for Environmental Life Sciences Engineering (SCELSE) annual scientific retreat last Thursday and Friday. Unfortunately, I was only able to attend the Thursday sessions, but I was very impressed by the work done there. It is virtually all basic science, but the results of the metagenomics […]

It was a great privilege to be invited for the conference organised by the University of Hong Kong’s Centre for Medical Ethics and Law in collaboration with their School of Public Health. Titled “Tackling Antimicrobial Resistance: Meeting the Global Challenge of AMR”, the organizers had invited a formidable line-up of local and international speakers, one […]
Dr Lam Pin Min, Senior Minister of State for the Ministries of Health and Transport, announced the launch of our National Strategic Plan on AMR during his address at the Public Health Thought Leadership Dialogue (PHTLD) organized by the Saw Swee Hock School of Public Health today. The document is available here, and broadly follows […]